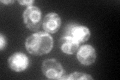
YDL212W
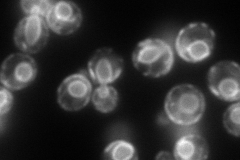
YDL212W
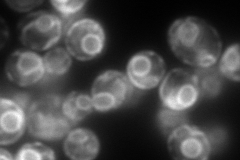
YDL212W
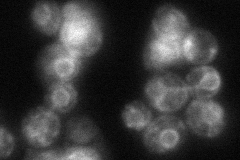
YDL212W
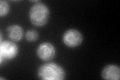
YDL212W
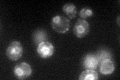
YDL212W

View description
Endoplasmic reticulum packaging chaperone, required for incorporation of amino acid permeases into COPII coated vesicles for transport to the cell surface
Localization:
Intensity:
Fold change:
Significance:
-
C’ GFP library in SD
ER71.06 -
N' NOP1pr-GFP in SD
ER215.43 -
N' TEF2pr-mCherry in SD
ER362.369 -
N' NATIVEpr-GFP in SD
ER52.7643 -
N' TEF2pr-VC and Cyto-VN in SD

ER49.4653 -
C’ GFP library in SD+DTT
ER81.551.14No -
C’ GFP library in SD+H2O2

ER61.670.86No -
C’ GFP library in Starvation Media
ER72.271.01No -
C’ GFP library on the background of Pup2-DaMP

ER -
C’ GFP library on the background of CCT mutant

ER69.54410.978467No
